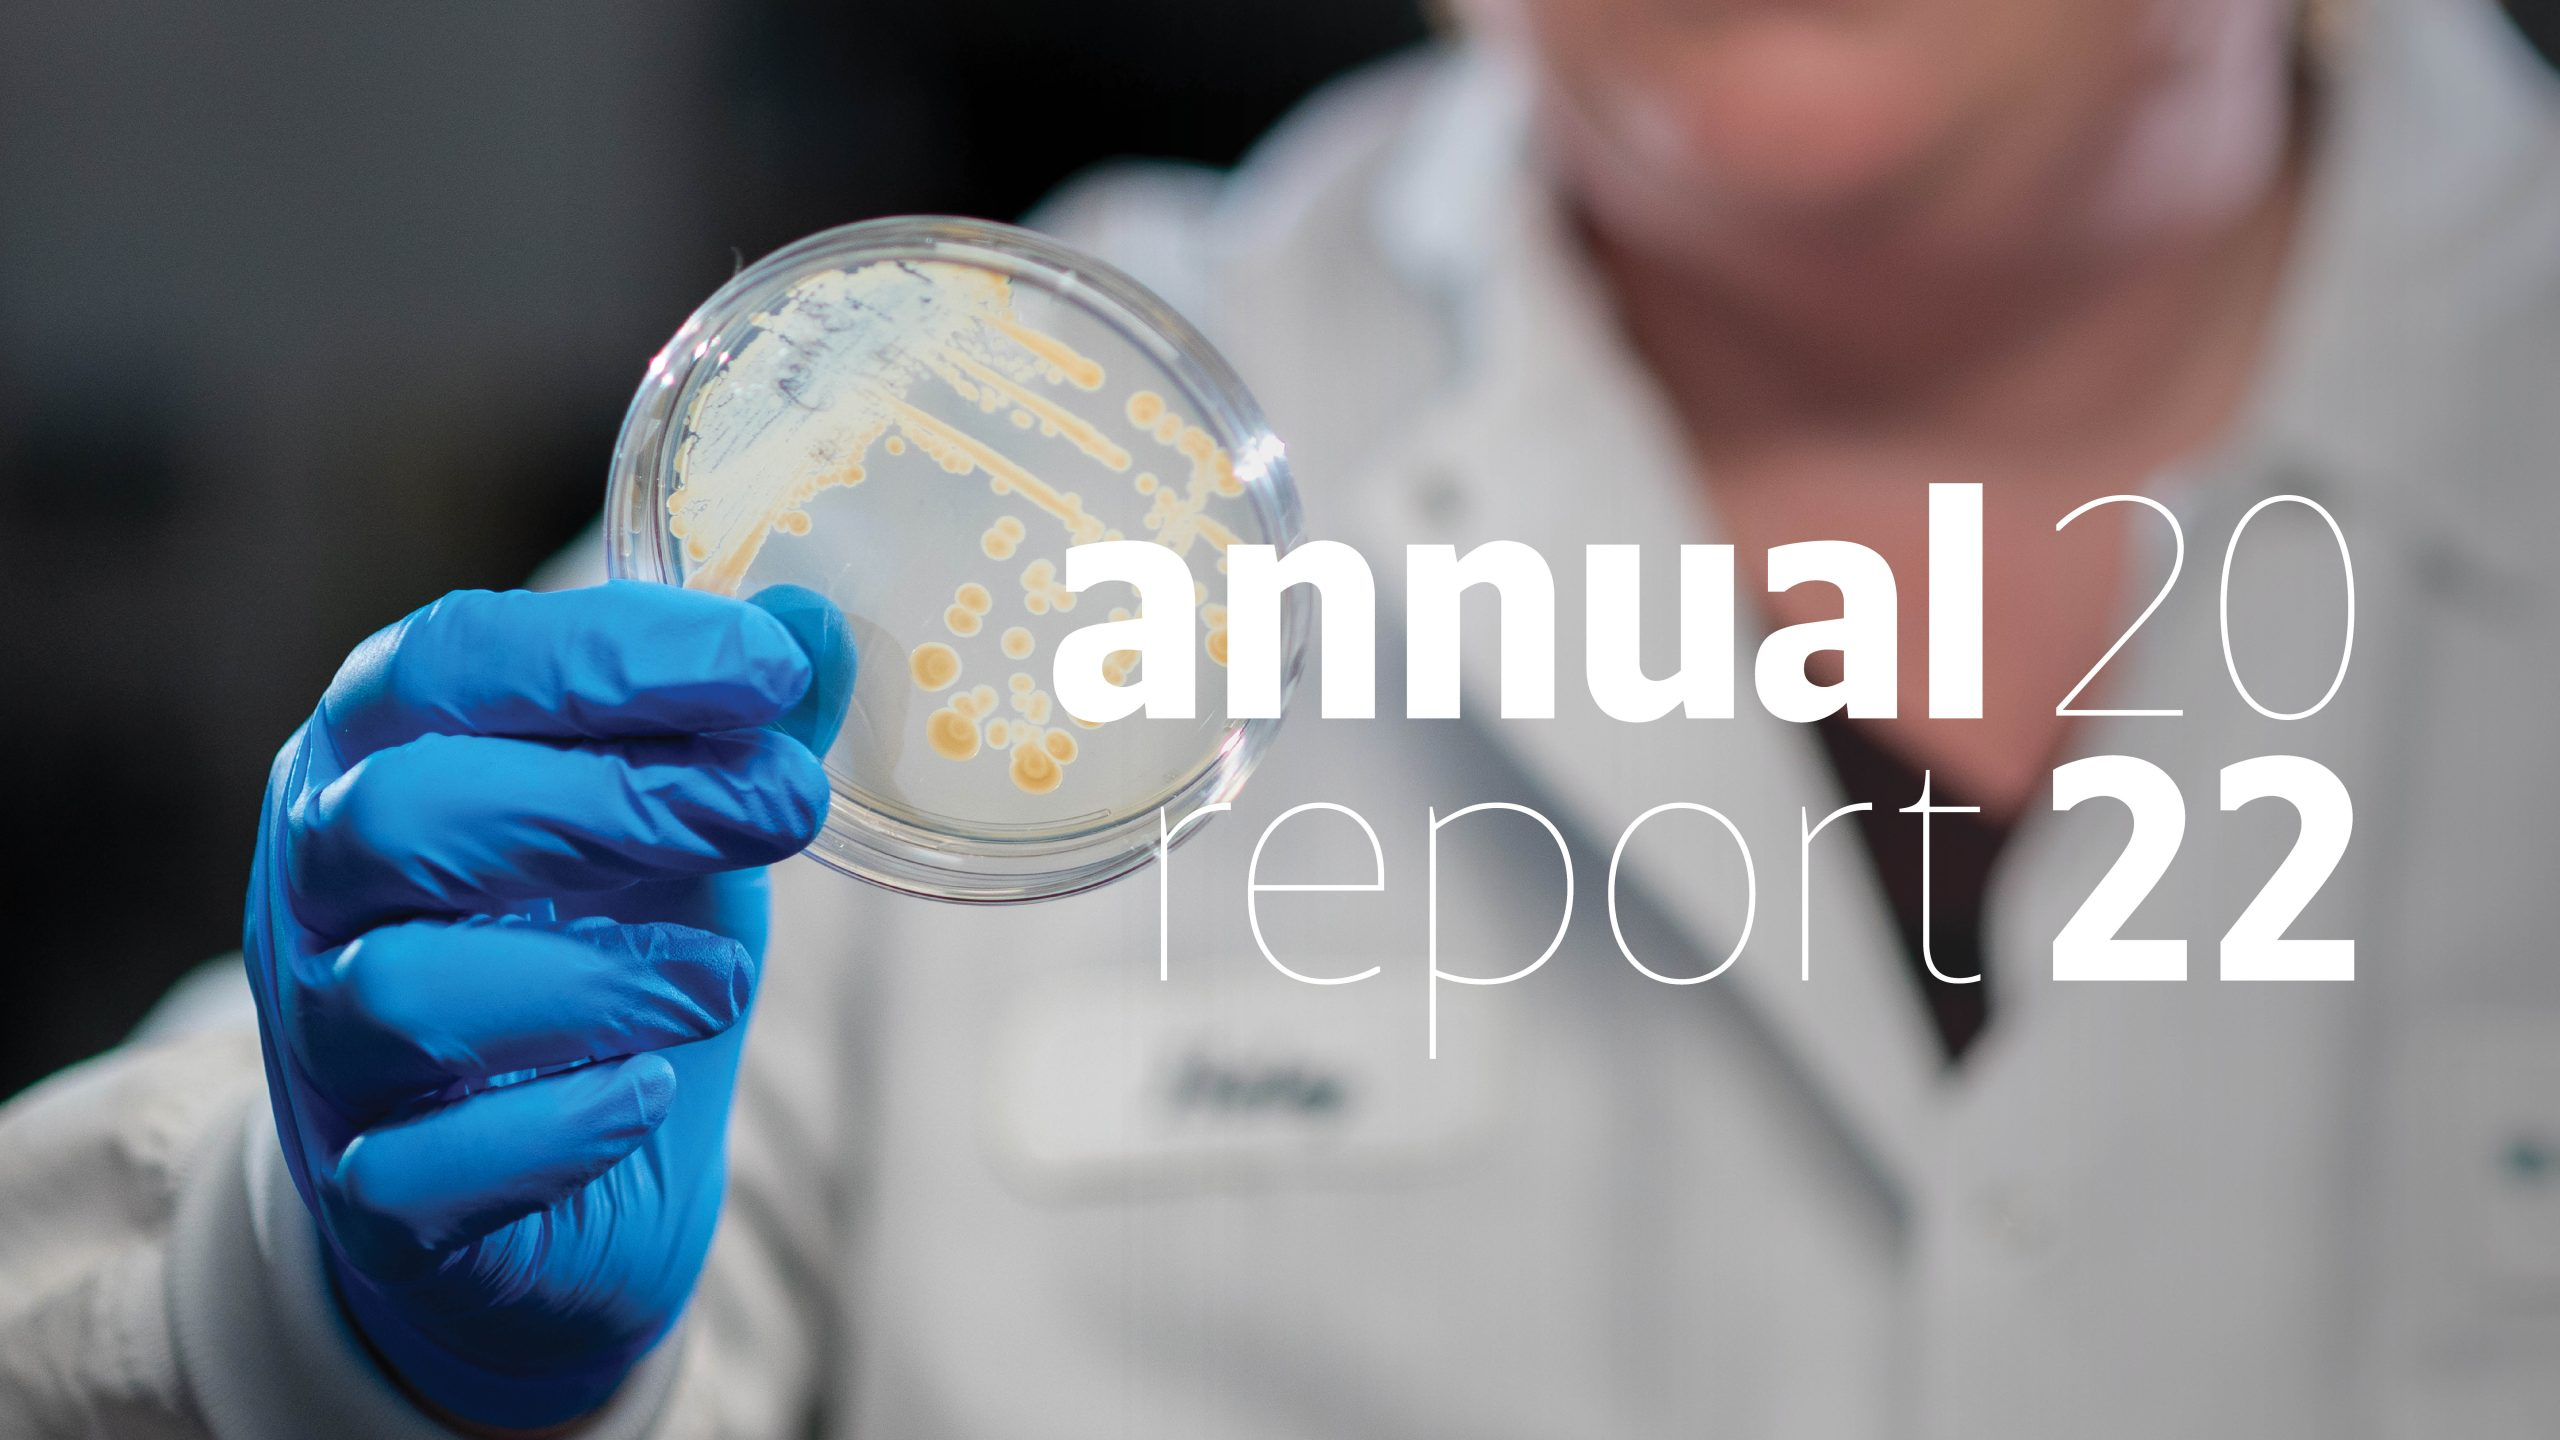

Reports
April 12, 2023
Copenhagen, Denmark – Novo Holdings today announced its financial results for 2022, with a negative -6% return on the Investment Portfolio and Total Income and Returns of DKK 3 billion (€0.4 billion). The positive Total Income and Returns of DKK 3 billion is driven by a strong performance by the Novo Group and resilience in the Investment Portfolio, which performed above benchmark.
Total Income and Returns of DKK 3 billion is comprised of Income from dividends and the share repurchase programmes of the Novo Group companies (Novo Nordisk A/S and Novozymes A/S), totalling DKK 14 billion (€2.0 billion), and Returns from the Investment Portfolio of -6% (versus the benchmark of -7%), corresponding to DKK -11 billion (€-1.6 billion). The 5- and 10-year trailing returns for the Investment Portfolio are 7% and 11%, respectively.
Novo Holdings closed 2022 with total assets of DKK 805 billion (€108 billion).
Kasim Kutay, CEO of Novo Holdings, said: “2022 was a very difficult year to navigate, with a significant downturn in both the equity and bond markets. Despite this backdrop, Novo Holdings was still able to report positive Total Income and Returns, driven by a strong performance by Novo Nordisk and Novozymes, as well as a strong relative performance by the Investment Portfolio.”
“2022 demonstrated the importance of the geographic and asset class diversification strategy we embarked upon back in 2019. In particular, our expansion in credit bonds, real estate and infrastructure helped the Investment Portfolio to deliver a good relative return,” Kasim said.
Increasing focus on bioindustrials
Investing in bioindustrial, or biosolutions, companies that deliver sustainable biological solutions to industry, continued to form a substantial investment theme for Novo Holdings in 2022. With 22 bioindustrial companies in the Investment Portfolio, Novo Holdings is today among the world’s most active investors in this sector.
December 12, 2022 was a historic day for the Novo Group and Novo Holdings, with the announcement of the proposed merger of Novozymes and Chr. Hansen, two of Novo Holdings’ largest shareholdings. The combination will create an industrial biosolutions powerhouse, strongly positioned to deliver long-term value to all stakeholders and to contribute to the green transition.
“Biosolutions are an important driver of the green transition of industry and society, and we are committed to maintaining our position as a world-leading investor in this sector,” said Kasim Kutay. “In late 2022 we established a dedicated Bioindustrials Investment team to better accommodate this growing part of our portfolio.”
High activity despite market turbulence
The Novo Holdings Investment Portfolio comprises Life Science Investments (Seed Investments, Growth Investments, Venture Investments and Principal Investments), making up 54% of the portfolio, and Capital Investments, which makes up 46% of the portfolio.
In 2022, Life Science Investments reported a negative DKK -6 billion
(€-0.9 billion) return, and Capital Investments closed the year with a negative DKK -5 billion (€-0.7 billion) return. By year-end, Novo Holdings was invested in 161 companies, up from 151 by the end of 2021.
“Despite the geopolitical and macro-economic headwinds, I am pleased that Novo Holdings was able to remain highly active and engaged on the investment front in 2022. Our Principal Investments team invested DKK 13 billion (€1.8 billion), including the acquisitions of three US-based companies. Our three other Life Science Investments verticals, namely Growth Investments, Venture Investments and Seed Investments, also remained active throughout the year and welcomed several new companies to our portfolio, while also managing a number of successful exits,” Kasim Kutay said.
“Our Capital Investments team closed the year with DKK 82 billion (€11.0 billion) of assets under management. The portfolio generated a return of -6% and a profit of DKK -5 billion (€-0.7 billion). The asset-class-weighted benchmark return for 2022 is -14%, so it’s fair to say that our Capital Investments team has successfully navigated the financial storms of 2022.”
2022 highlights
The Novo Group Companies, Novo Nordisk A/S and Novozymes A/S delivered historically strong results. Novo Nordisk’s sales increased by 26% in DKK and by 16% at constant exchange rates, and Novozymes reported 9% organic sales growth in 2022, marking the highest organic sales growth in more than a decade.
Capital Investments continued to expand its real estate portfolio during 2022, including increasing its stake in Dades, one of the largest real estate investment firms in Denmark. The Capital Investments team committed €700 million to 7 portfolio managers within Real Assets. A highlight was a €265 million commitment to Glentra, a newly established infrastructure fund and an investment into 18 solar projects in Spain through our investment into Spain-based Everwood Capital Fund V.
Principal Investments deployed DKK 13 billion of equity into three private US control investments (Medical Knowledge Group, The Ritedose Corporation, and KabaFusion), and four investments in publicity listed US companies. The most significant exit took place in the second half of the year, involving Envirotainer, a global provider of mission-critical, temperature-controlled air cargo services for the pharmaceutical industry. Owned by Novo Holdings and Cinven, Envirotainer was sold to EQT and Mubadala at an enterprise value of €8 billion, generating an IRR of 28.9%.
Growth Investments executed 4 new investments and 8 follow-on investments during 2022, deploying DKK 2 billion. The value of the Growth Investments portfolio was DKK 8 billion at the end of 2022, slightly higher than by the end of 2021. At the end of the year, the Growth Investments portfolio comprised investments in 26 companies.
Venture Investments executed 38 investments during 2022, deploying DKK 3 billion. During the year, the Venture Investments team helped Arcellx execute an Initial Public Offering (IPO). Later in 2022, Arcellx completed a follow-on offering, raising over USD 270 million in total in the public capital markets in 2022. At the end of 2022, the portfolio was valued at DKK 11.2 billion. The portfolio included 54 companies, of which 57% were public and 43% private.
Seed Investments invested in three new companies including the launch of Breye Therapeutics. Further, the team was among the cornerstone investors in Sound Bioventures Fund I. The Seed Investments team divested two portfolio companies: Syndesi Therapeutics was acquired by AbbVie with a total deal value of up to USD 1 billion and USD 130 million upfront. BioPhero ApS was acquired by FMC Corporation for approximately USD 200 million. By the end of 2022, the Seed portfolio counted 40 companies, and was valued at DKK 3 billion.
The following table shows the 5- and 10-year returns for Life Science Investments, Capital Investments and the Total Investment Portfolio. The results for 2021 are included for comparison along with the long-term returns.

As a holding and investment company, Novo Holdings invests to generate long-term returns. The Total Value of the Holding and Investment Assets was DKK 805 billion (EUR 108 billion) at the end of 2022.

Notes: Income from the Novo Group includes dividends received from Novo Nordisk A/S and Novozymes A/S, in addition to income related to the sale of shares in Novo Group companies. In the investment assets overview, the value of the Novo Group is presented with both A and B shares valued at the closing price of B shares on 31 December 2022 and 31 December 2021. Income and Investment Returns as well as Total Holdings and Investment Assets include the Novo Nordisk Foundation’s share of returns and assets.
All returns are calculated in DKK and reflect total returns excluding internal costs. The returns on Life Science Investments are calculated as internal rate of return (IRR) based on the book value at the end of the measurement period and cash flows within the measurement period, compared with the book value at the beginning of the measurement period. Capital Investments’ returns and Investment Portfolio returns are based on Time Weighted Returns (TWR).
Read the Novo Holdings Annual Report 2022 here.
About Novo Holdings A/S
Novo Holdings is a holding and investment company that is responsible for managing the assets and wealth of the Novo Nordisk Foundation. The purpose of Novo Holdings is to improve people’s health and the sustainability of society and the planet by generating attractive long-term returns on the assets of the Novo Nordisk Foundation.
Wholly owned by the Novo Nordisk Foundation, Novo Holdings is the controlling shareholder of Novo Nordisk and Novozymes (the Novo Group companies) and manages an investment portfolio with a long-term return perspective. In addition to managing a broad portfolio of equities, bonds, real estate, infrastructure and private equity assets, Novo Holdings is a world-leading life science investor. Through its Seeds, Venture, Growth and Principal Investments teams, Novo Holdings invests in life science companies at all stages of development.
As of year-end 2022, Novo Holdings had total assets of €108 billion. Further information: www.novoholdings.dk.
About the Novo Nordisk Foundation
Established in Denmark in 1924, the Novo Nordisk Foundation is an enterprise foundation with philanthropic objectives. The vision of the Foundation is to improve people’s health and the sustainability of society and the planet. The Foundation’s mission is to progress research and innovation in the prevention and treatment of cardiometabolic and infectious diseases as well as to advance knowledge and solutions to support a green transformation of society.
www.novonordiskfonden.dk/en
Further information
Marie-Louise Jersin, Senior Communications Partner, +45 3049 4957, maj@novo.dk